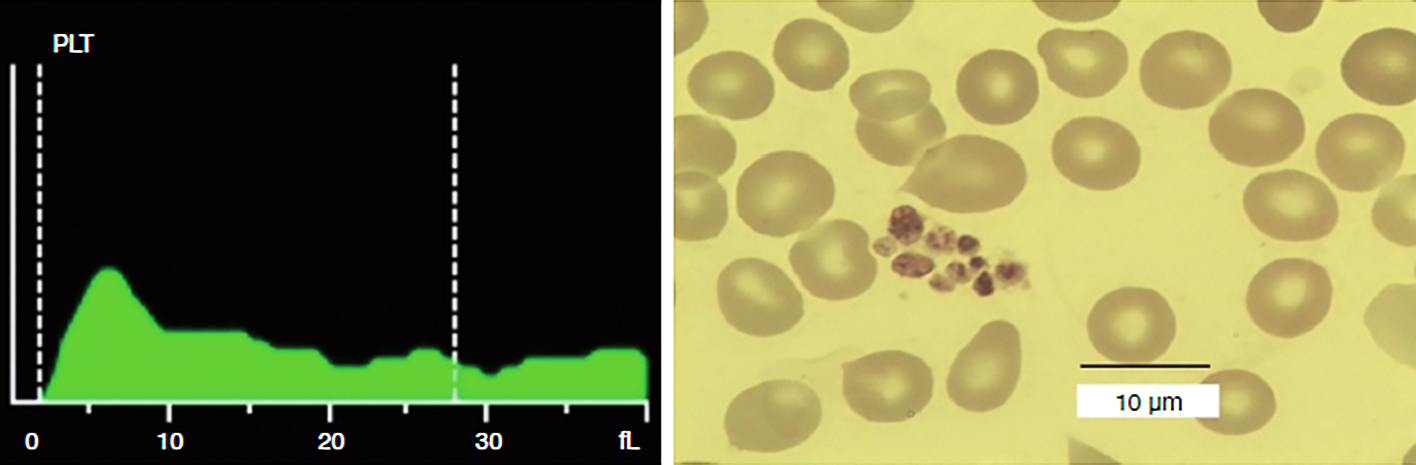
20200916125605_3587

HemaBook CapĂtulo 2: ?Una opciĂłn mĂĄs para solucionar problemas de EDTA-PTCP?
Mindray 2021-01-13

La pseudotrombocitopenia inducida por ĂĄcido etilendiaminotetraacĂ©tico: (EDTA-PTCP) es un âartefactoâ, de laboratorio que puede provocar una evaluaciĂłn incorrecta y un tratamiento innecesario de los pacientes.
?
?CuĂĄl de los siguientes mĂ©todos (o mĂ©todos) utilizarĂa para corregir los recuentos de plaquetas en caso de una agregaciĂłn plaquetaria inducida por EDTA en la trombocitopenia?
- Reanalizar con un frotis de sangre y estimar el recuento de plaquetas
- Reanalizar con la adiciĂłn de amikacina
- Reanalizar después de calentar a 37 °C
- Reanalizar inmediatamente la diluciĂłn sin anticoagulante
- Reanalizar en otro analizador hematolĂłgico
- Reanalizar con otros anticoagulantes

Los profesionales que trabajan en laboratorios clĂnicos buscan la precisiĂłn y la veracidad de resultados con el mayor sentido de responsabilidad. Se han realizado recientemente algunos estudios clĂnicos para explorar las soluciones EDTA-PTCP, y se sugiere que los sistemas de hematologĂa Mindray con tecnologĂa SF Cube serĂan una opciĂłn para ayudar eficazmente a los tĂ©cnicos de laboratorio a identificar los recuentos plaquetarios correctos.

Informe de un caso clĂnico
La paciente es una mujer de 32 a?os con infertilidad. DespuĂ©s de extraer la sangre en un tubo con anticuagualante EDTA, se analizĂł dentro de los 55 minutos y mostrĂł un recuento plaquetario bajo (28 Ă 109/L). La prueba se realizĂł mediante el mĂ©todo de impedancia (PLT-I) en un sistema de hematologĂa de una marca conocida (aparato A). La agregaciĂłn plaquetaria se confirmĂł mediante examen microscĂłpico del frotis, que indicaba pseudotrombocitopenia (PTCP). Poco despuĂ©s, se realizĂł un nuevo anĂĄlisis de esta muestra utilizando el mĂ©todo CDR (PLT-O) en el Mindray BC-6800Plus. Los resultados mostraron un recuento de plaquetas marcadamente mĂĄs alto con un valor de 180 Ă 109/L.

Se sospecha que el bajo recuento plaquetario obtenido en el aparato A se debió a agregación plaquetaria inducida por EDTA. A continuación, se le pidió a la paciente que autorizara un anålsis adicional utilizando esta vez un tubo de ensayo de sangre con citrato de sodio. La muestra se analizó treinta minutos después de la extracción. En la Tabla 1 se indican los paråmetros plaquetarios resultantes de las muestras de sangre analizadas mediante varios métodos y aparatos de anålisis.

ComparaciĂłn adicional de otras muestras
Bajo la evaluaciĂłn microscĂłpica del frotis de sangre, la sangre anticoagulada con EDTA mostrĂł agregaciĂłn plaquetaria mientras que la sangre anticoagulada con citrato de sodio no mostrĂł ninguna. Las muestras de sangre se analizaron dentro de las cuatro horas de la extracciĂłn, de acuerdo con las instrucciones del fabricante. AdemĂĄs de esa paciente, se recopilaron y evaluaron los datos de cinco casos adicionales de EDTA-PTCP (Tabla 2).

Al final, el autor concluye: En pacientes con EDTA-PTCP conocida o sospechada, la tecnologĂa Mindray SF-Cube es una forma sencilla y eficaz de determinar el recuento de plaquetas en sangre anticoagulada con EDTA.

IdentificaciĂłn y caracterĂsticas de las muestras de EDTA-PTCP
Las muestras que activaron el indicador de âagregaciĂłn PLTâ en el analizador de hematologĂa mostraron una irregularidad dentada tĂpica y una cola en zigzag (Figura 1) en el histograma plaquetario. AdemĂĄs, bajo evaluaciĂłn microscĂłpica, no se observa la presencia de satelitismo plaquetario o plaquetas gigantes.
Bajo recuento plaquetario errĂłneo mediante recuento de plaquetas Ăłptico (PLT-O) en el BC-6800
?
Se analizaron 23 muestras de EDTA-PTCP en tubos de EDTA (con agregación plaquetaria) en los canales de impedancia (PLT-I [EDTA]) y de reticulocitos del Mindray BC-6800 (PLT-O [EDTA]). Curiosamente, los resultados de PLT-O (EDTA) fueron comparables a los recuentos de plaquetas de las muestras recogidas en tubos de citrato (PLT-I [Citrato]), lo que demuestra que el método PLT-O (EDTA) puede ajustarse con precisión para el problema de agregación plaquetaria causado por EDTA (Figura 2).

Efecto de disociaciĂłn EDTA-PTCP en el sistema hematolĂłgico de una conocida marca:?Disponible con tinciĂłn fluorescente?
El recuento de plaquetas por fluorescencia Ăłptica estĂĄ disponible tanto en analizadores de hematologĂa de gama alta (aparato B) como en los analizadores de hematologĂa de la serie Mindray BC-6000. En este mĂ©todo, se usa una tinciĂłn fluorescente para te?ir los ĂĄcidos nucleicos en las plaquetas, lo que permite el reconocimiento de plaquetas grandes y excluye las partĂculas que no son plaquetas, como restos de eritrocitos, microeritrocitos o leucocitos.

Para verificar si el efecto de disociaciĂłn del recuento de plaquetas de fluorescencia Ăłptica dependĂa de la tinciĂłn con colorante fluorescente, 17 de esas 23 muestras de EDTA-PTCP en tubos de EDTA tambiĂ©n se probaron en el canal de reticulocitos y el canal de impedancia del aparato B. No se encontrĂł diferencia entre los recuentos plaquetarios del canal de reticulocitos y el canal de impedancia (Figura 3). Solo una de las 17 muestras de EDTA-PTCP mostrĂł una tasa de disociaciĂłn de mĂĄs del 80?%, con una tasa de disociaciĂłn promedio del 56?% entre las 17 muestras de EDTA-PTCP (Figura 3).
ConclusiĂłn
El autor concluye, en resumen: El recuento de plaquetas mediante fluorescencia Ăłptica del analizador hematolĂłgico BC-6800 es eficaz para la correcciĂłn de falsos recuentos plaquetarios bajos en pacientes con EDTA-PTCP, y su efecto de disociaciĂłn en muestras de EDTA-PTCP es independiente de la tinciĂłn con colorante fluorescente.
?

En el trabajo diario del laboratorio, la apariciĂłn de la pseudotrombocitopenia (PTCP) es un problema inevitable. La tecnologĂa Mindray SF Cube proporciona mediciones de PLT-O (basado en tinciĂłn fluorescente de ĂĄcido nucleico y efectuadas en el canal RET) para corregir los recuentos de PLT cuando hay una pseudorreducciĂłn de plaquetas debida a EDTA. PLT-O estĂĄ disponible en el analizador automĂĄtico de hematologĂa de la serie BC-6000 de Mindray y en la lĂnea de anĂĄlisis histolĂłgico CAL 8000/6000.
Referencias:
[1] J. Deng, et al. Mindray SF-Cube technology: An effective way for correcting platelet count in individuals with EDTA dependent pseudo thrombocytopenia. Clinica Chimica Acta 502 (2020) 99â101
[2] Y. Bao, et al. Correction of spurious low platelet counts by optical fluorescence platelet counting of BC-6800 hematology analyzer in EDTA-dependent pseudo thrombocytopenia patients. Transl Cancer Res 2020;9(1):166-172












